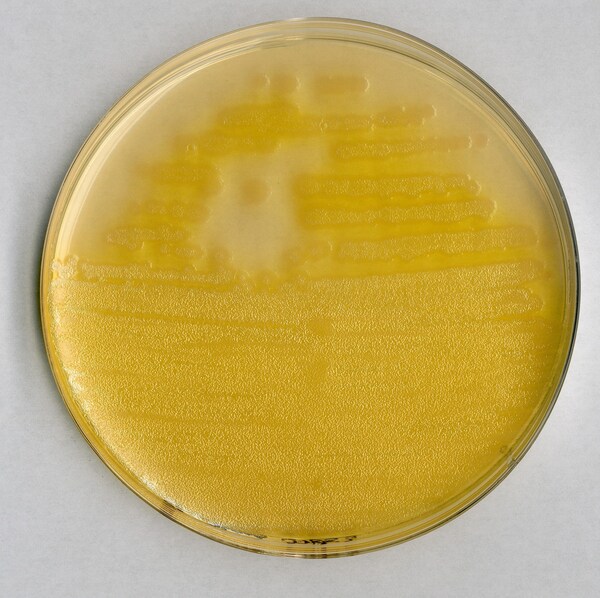
1109890500.JPG

* Imagem meramente ilustrativa
AGAR F PARA PSEUDOMONAS 500GR MERCK
Modelo: 1109890500
R$ 1.984,03
ou até 3x de R$ 661,34 sem juros
Economize 5% no PIX: R$ 1.884,83
ou 3,5% no boleto: R$ 1.914,59
Calcular Frete
Descrição
PSEUDOMONAS AGAR F BASE MERCK
RENDIMENTO 35,0g/l
EMBALAGEM 500GR
This media comply with the recommendations of the United States Pharmacopeia XXVI (2003) and correspond to the culture media specified in the DIN Norm 38411 (examination of water).
Mode of Action
Pseudomonas Agar P favours the formation of pyocyanin and/or pyorubin and reduces that of fluorescein, whereas Pseudomonas Agar F stimulates the production of fluorescein and reduces that of pyocyanin and/or pyorubin. Simultaneous use of both culture media allows rapid, preliminary identification of most Pseudomonas species, as some strains can only synthesize pyocyanin, some form only fluorescein and others produce both
pigments.
Typical Composition (g/litre)
Peptone from casein 10.0; peptone from meat 10.0; magnesium sulfate 1.5; di-potassium hydrogen phosphate 1.5; agar-agar 12.0.
Also to be added: glycerol 10.0 ml.
Preparation
Suspend 10.0 ml glycerol/litre together with 35 g Pseudomonas Agar F Base/litre, dispense into test tubes if desired, autoclave (15 min at 121 °C). Make slant tubes or pour plates.
pH: 7.2 ± 0.2 at 25 °C.
The plates are clear to opalescent and yellowish-brown.
